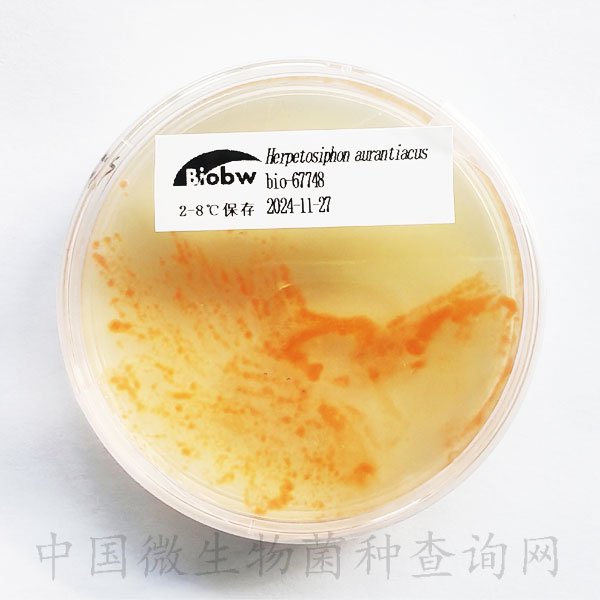
技术资料图片1

3 年
手机商铺
技术资料/正文
136 人阅读发布时间:2024-11-29 10:18
一、菌种简介
平台编号:bio-67748
ATCC 23779=DSM 785
培养基编号:174
培养温度:30
培养基编号:174
名称:DSM#67 CY-AGAR
推荐生产厂家:
可用于培养菌种:
备注:Casitone(酪蛋白胨)3.00 g Yeast extract 1.00 g CaCl2 x 2 H2O 1.36 g Agar 15.00 g Distilled water 1000.00 ml Adjust pH to 7.2.
二、培养基

三、保藏条件
斜面菌种和安瓿瓶冻干菌种应在2~8°C保存。西林瓶请置于-20°C保存。甘油管请置于-80°C保存;请勿长期置于室温。
注意事项
1)冻干粉首次活化,干粉要全部用完,不能预留,用无菌吸管吸取0.3ml的培养液(即以上建议的培养基配方,不加琼脂)或者无菌水,滴入冻干管中,轻轻振荡至其溶解。吸取全部菌悬液,接种在培养基上(建议不超过2支斜面或平板;或直接接种液体培养基,以不超过5ml为宜);
2)经过冷冻干燥保藏,菌种处于休眠状态,复苏培养时可能会延迟生长,这时需较长的培养时间;若您收到的是已复苏的培养物(非冻干菌),则可以直接用于您的实验,或根据需要转接培养如有不明白之处,请务必先咨询我单位技术人员,避免不必要的损失;
3)微生物菌种应保藏于低温、清洁干燥的地方,室温放置时间过长会导致菌种衰退;
4)菌种操作应在无菌条件下进行;转种完毕,应经灭菌再做丢弃处理;
5)应根据菌种状况及时转接,冻干菌种保藏时间通常为2-25年;
6)菌种使用过程中如出现杂菌污染或菌种生产性能下降或不活,请在收到后2个月内和微生物菌种查询网联系,逾期不予受理;
7)打管操作需由专业微生物技术人员在相应的防护设备中进行,生物危害程度为三类的菌种应在生物安全柜中操作,打管时冻干管应远离面部,保护眼睛。
8)安瓿瓶开封:用浸过75%酒精的脱脂棉擦净安瓿管,用火焰加热其顶端,滴少量(2-3滴)无菌水至加热顶端使之破裂,用锉刀或者镊子敲下已破裂的安瓿管顶端并将冻干管开口处在火焰上过一遍,并保持在火焰旁操作。
9)甘油管使用:使用本甘油菌时可以不用完全融解,在甘油菌表面蘸取少量涂板或进行液体培养即可。也可以完全融解后使用,但随着冻融次数的增加,细菌的活力会逐渐下降。
10)西林瓶开封:用75%酒精棉擦拭西林瓶外部,在安全柜内使用尖嘴钳去除塑料盖及铝盖,注意不要同时打开胶塞。缓慢开启胶塞,用75%酒精棉消毒瓶口部分,使用无菌吸管注入0.5ml适宜的液体培养基复溶冻干粉末。
微生物菌种查询网是一个专为科研人员进行微生物菌种查询的技术型网站,由包括北京百欧博伟生物技术有限公司在内的多家企事业单位及院所共同打造!网站隶属于北京百欧博伟生物技术有限公司,并由其进行更新维护,会根据资源内容及菌种数量进行不定时更新,旨在将最全面的微生物菌种信息呈现给广大微生物科研技术人员!
从成立之日至今,微生物菌种查询网已收录并更新的国内外菌种资源达12万余株,其中,国内7万余株,国外4万余枚!网站也对细胞资源信息进行了收录,目前达到了国内外细胞资源总量超过1万余枚,基本可以满足大部分科研人员的查询需求!同时我们也罗列了5千余套培养基配方,部分已以文字的形式免费呈现在网站中!而且我们技术人员已经在对常用质粒载体进行设计构建,并且可提供查询的有400余枚!经过工作人员的不懈努力,网站中的资源信息每天都在增加,信息内容每天都在丰富,方便了大批需要进行微生物查询的科研技术人员,满足了众多企事业单位及科研院所的需求!